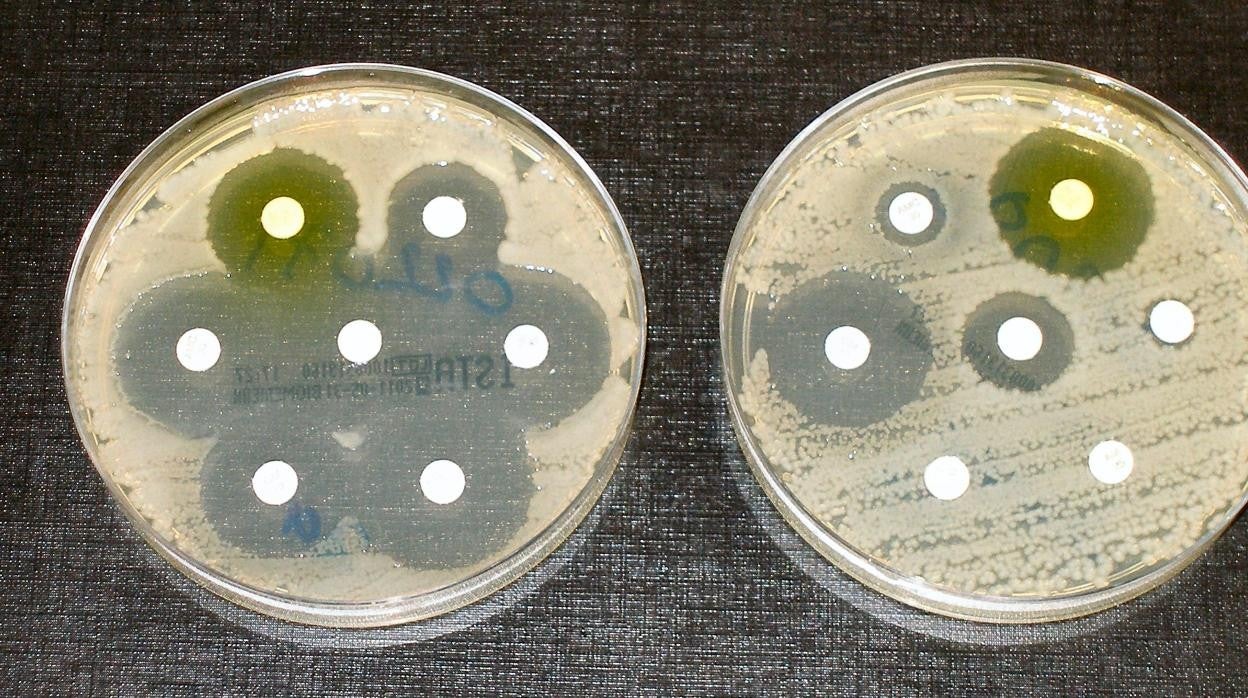
Cultivo

Los antibióticos se relacionan con un mayor riesgo de cáncer de colon a 10 años
Un estudio publicado en «Journal of Clinical Investigation» señala que el impacto de los antibióticos sobre el microbioma intestinal está detrás de este mayor riesgo de cáncer
R. I.
El consumo de antibióticos se relaciona con un mayor riesgo de desarrollar cáncer de colon en los próximos cinco a diez años. Lo acaba de confirmar un estudio llevado a cabo por investigadores de la Universidad de Umeå (Suecia), realizado en más , 40.000 ... casos de cáncer. Los investigadores creen que el impacto de los antibióticos sobre el microbioma intestinal está detrás de este mayor riesgo de cáncer.
Los resultados, escriben los investigadores cuyo trabajo se publica en « Journal of Clinical Investigation » subrayan el hecho de que hay muchas razones para ser restrictivo con la prescripción de antibióticos.
«Aunque en muchos casos la terapia con antibióticos es necesaria y salva vidas, en enfermedades menos graves se debe tener precaución. Especialmente para evitar que las bacterias desarrollen resistencia, pero, como muestra este estudio, también porque los antibióticos pueden aumentar el riesgo de cáncer de colon en el futuro », explica Sophia Harlid, investigadora de la Universidad de Umeå.
El aumento del riesgo es moderado y el efecto sobre el riesgo absoluto para el individuo es bastante pequeño
Los investigadores han visto que tanto las mujeres como los hombres que tomaron antibióticos durante más de seis meses tenían un riesgo un 17% mayor de desarrollar cáncer en el colon superior, la primera parte del colon a la que llegan los alimentos después del intestino delgado, que aquellos que no habían tomado antibióticos.
Sin embargo, no se encontró un mayor riesgo de cáncer en el colon descendente.
Tampoco hubo un mayor riesgo de cáncer de recto en los hombres que habían sido tratados con antibióticos, mientras que las mujeres que tomaban antibióticos tenían una incidencia ligeramente menor de cáncer de recto.
El aumento del riesgo de cáncer de colon, escriben los investigadores, ya era visible a los cinco o diez años después de la ingesta de antibióticos.
El aumento del riesgo de cáncer de colon, escriben los investigadores, ya era visible a los cinco o diez años después de la ingesta de antibióticos.
Aunque este incremento fue mayor para quienes tomaron la mayoría de los antibióticos, también se observó un aumento pequeño, pero estadísticamente significativo, en el riesgo de cáncer después de un solo ciclo de antibióticos.
El estudio utiliza datos sobre 40.000 pacientes del Registro Sueco de Cáncer Colorrectal del período 2010-2016 que se han comparado con un grupo de control emparejado de 200.000 individuos sin cáncer extraídos de la población sueca.
Los datos sobre el uso de antibióticos de las personas se obtuvieron del Registro de Medicamentos Recetados de Suecia para el período 2005-2016. El estudio sueco confirma ampliamente los resultados de un estudio británico anterior, algo más pequeño.
Incluso los antibióticos intravenosos pueden afectar la microbiota intestinal en el sistema intestinal
Para comprender cómo los antibióticos aumentan el riesgo, los investigadores también estudiaron un fármaco bactericida no antibiótico utilizado contra las infecciones urinarias que no afecta el microbioma. No hubo diferencia en la frecuencia de cáncer de colon entre quienes usaron este medicamento, lo que sugiere que es el impacto de los antibióticos en el microbioma lo que aumenta el riesgo de cáncer.
Si bien el estudio solo cubre los antibióticos administrados por vía oral, incluso los antibióticos intravenosos pueden afectar la microbiota intestinal en el sistema intestinal.
No obstante, los investigadores no quieren ser alarmistas. «No hay absolutamente ningún motivo de alarma simplemente porque haya tomado antibióticos. El aumento del riesgo es moderado y el efecto sobre el riesgo absoluto para el individuo es bastante pequeño», matiza Sophia Harlid.
Límite de sesiones alcanzadas
- El acceso al contenido Premium está abierto por cortesía del establecimiento donde te encuentras, pero ahora mismo hay demasiados usuarios conectados a la vez. Por favor, inténtalo pasados unos minutos.
Has superado el límite de sesiones
- Sólo puedes tener tres sesiones iniciadas a la vez. Hemos cerrado la sesión más antigua para que sigas navegando sin límites en el resto.
Esta funcionalidad es sólo para suscriptores
Suscribete
Esta funcionalidad es sólo para registrados
Iniciar sesiónEsta funcionalidad es sólo para suscriptores
Suscribete